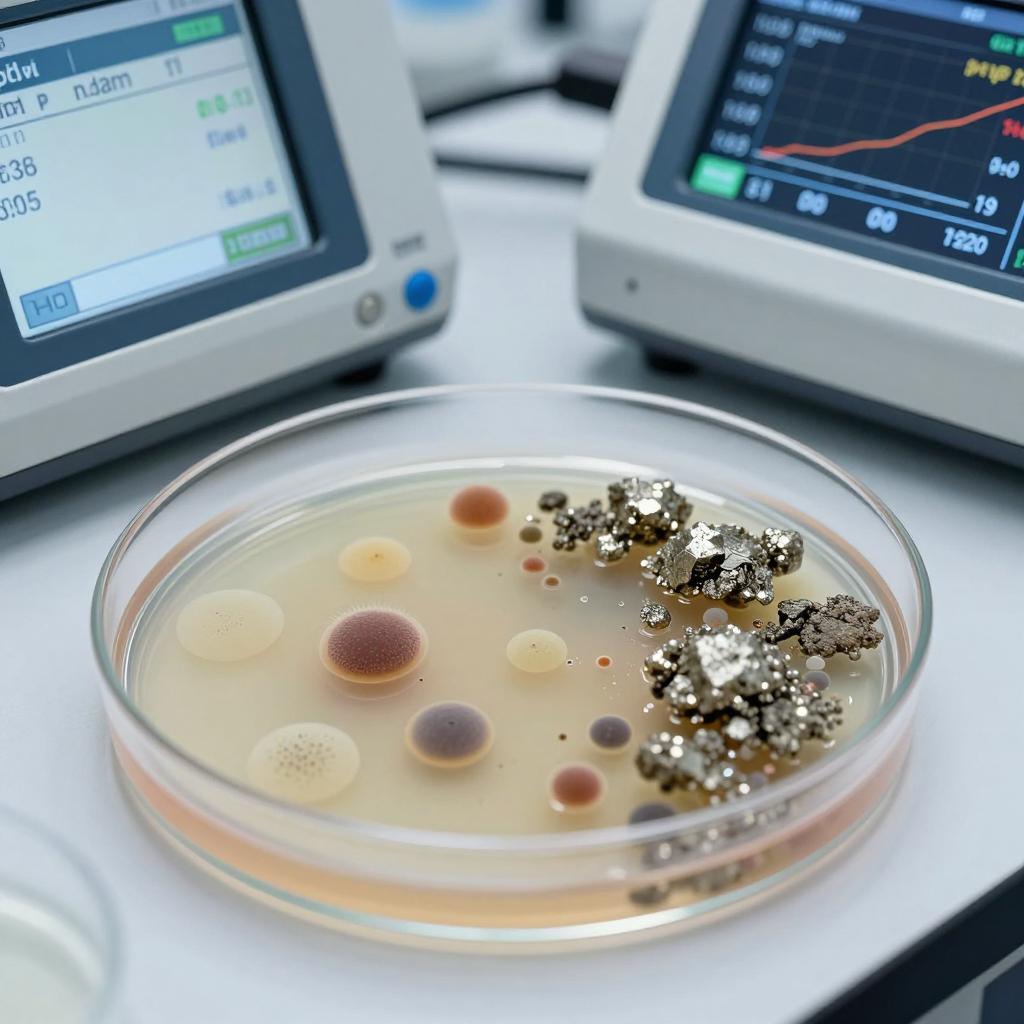
铁矿中伴生金属元素回收利用新工艺有所突破 铁矿中伴生金属元素回收利用新工艺有所突破第一张图

【摘要】为解决攀西地区钒钛磁铁矿中伴生铜、镍、钴等金属元素回收难、利用率低等难题,中国地调局成都综合所近日研究开发了一种利用微生物溶浸回收铁矿中伴生金属元素的新工艺。
为解决攀西地区钒钛磁铁矿中伴生铜、镍、钴等金属元素回收难、利用率低等难题,中国地调局成都综合所近日研究开发了一种利用微生物溶浸回收铁矿中伴生金属元素的新工艺。
该方法针对伴生铜、镍、钴等金属元素的铁矿石,在磨矿-磁选回收铁以前对矿石中伴生的铜、镍、钴等金属元素进行生物处理,并回收利用。该工艺方便回收,可大大提高伴生金属的回收率。目前,该项工艺技术已获得了国家发明专利。
该发明利用含铁离子的稀硫酸溶液对铁矿石中伴生铜、镍、钴元素的氧化溶解作用,通过控制较高的喷淋液温度,实现氧化反应的快速进行,在较短的时间内将铁矿中的伴生铜、镍、钴金属元素溶出并回收。
与此同时,对反应后的喷淋液进行生物氧化,实现铁离子的快速再生,有效降低了氧化试剂消耗,节约了生产成本。在整个工艺流程内,溶液实现了闭路循环,是清洁高效的绿色工艺。
该方法的应用推广,将显著提高铁矿中伴生铜、镍、钴金属元素的回收效率,提高资源综合利用率,大大增加企业的经济收入。
该发明特别适用于伴生铜、镍、钴等金属元素的钒钛磁铁矿中,可以有效提高伴生铜、镍、钴等金属元素的回收利用率。